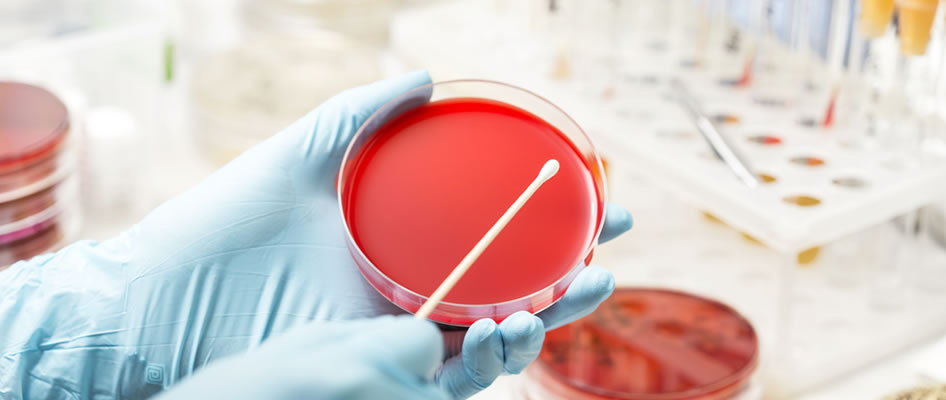

消费品/纺织/玩具检测
中邦为您提供专业文具、儿童玩具、印刷品、宠物食品检测服务,随着经济发展,不仅越来越多的消费品生产企业需要对其产品质控有强需求,我们为您的企业产品力提供支撑。
我们拥有10多年的产品测试经验,能够提供独立的、反应迅速,并且节约成本的测试服务,帮助您缩短将产品推向市场的时间,降低风险,提升产品的市场价值。通过广布全球的实验室和办事处网络,我们提供优质便捷的本地服务。
-

箱包、皮革制品的检测
中邦将全方位为您提供箱包测试一站式服务,包括:拉杆箱、行李箱、旅行箱包、书包、背提包等测试服务,从原料配件到产品销售,从源头管控产品质量,为零售商、制造商、采购商及电商平台进驻上新提供助力支持,确保箱包产品符合整个供应链要求,为您制胜市场保驾护航!¥ 0.00立即购买
-

童车检测
童车——适用于设计或预定供儿童乘骑玩耍的童车类产品,包括:儿童自行车( 鞍座高度在435mm~635mm范围内),儿童三轮车,儿童推车,婴儿学步车,玩具自行车( 鞍座高度小于435mm),电动童车,其它玩具车辆 。消费者越来越关注他们选购的产品安全性和质量,尤其是儿童和婴幼儿产品。若产品不符合安全标准和法规要求,可能对婴儿、幼儿和儿童造成威胁。¥ 0.00立即购买
-

AZO偶氮检测
随着生活水平的日益提升,对服装及纺织品的质量要求越来越严格。由于违禁的AZO偶氮染料(或可分解芳香胺染料)会分解出致癌物质,严重影响身体健康;而且该类染料通常无色无味,不能通过人体的感觉器官感知,甚至不能通过洗涤等方式来减轻其危害,所以外的纺织品标准均禁用这类染料。¥ 0.00立即购买
-

婴幼儿湿巾防腐剂检测
CIT全名为甲基氯异噻唑啉酮,是一种防腐剂成分,常与另外一种防腐剂甲基异噻唑啉酮(MIT)混合使用于水性化妆品中。CIT对于肌肤与黏膜有刺激性,不适合添加于长时间接触的产品中。曾有新闻爆出某地市场销售的婴幼儿湿巾中有近半数产品检出CIT,不少产品CIT含量更是高于普通湿巾。¥ 0.00立即购买
-

童装检测
儿童作为不具备或不完全具备自我保护能力的特殊人群,其生活用品的设计和生产均有特殊的要求。儿童服装在设计和生产过程中,除了考虑威胁人类安全的常规因素外,还要考虑其行为特点和心理特点。近年来,社会对儿童服装安全方面日益重视,相继出台多项法规以保护儿童身心健康发展。¥ 0.00立即购买
-

荧光增白剂检测
荧光增白剂不像一般化学成分那样容易被分解,直接接触后有可能进入人体,在人体内蓄积,产生许多有害的作用,大大削减人体免疫力。荧光剂与伤口外的蛋白质结合,会阻碍伤口的愈合。荧光剂能使人体细胞出现变异性倾向,其毒性累积在肝脏或其他重要器官,会成为潜在的致癌因素。¥ 0.00立即购买
-

抗菌材料检测
抗菌检测就是检测一些材料对微生物的抑止作用。抗菌检测按照菌种分类可以分为两大类,即:细菌检测和霉菌检测¥ 0.00立即购买
一站式检验检测服务专家
服务热线:400-115-9001
中邦检测(山东中邦北方管理咨询有限公司),国内规模较大成立较早的检验检测服务机构,为全球客户提供多元化、一站式检测认证服务。 公司成立于2011年,在全国拥有青岛、杭州两大运营中心,1 5家子公司。拥有各类国际/国内认证资质(焊接/无损检测/涂装等)工程师40余人,凭借经验丰富的工程师团队和先进的管理理念,当前业务已覆盖中国大部分地区,拥有数百家优质客户,其中包括众多知名企业、集团和政府机构。长期专注于电子电气、日用消费品、新能源新材料、环境检测、食品检测领域检测认证服务。
商务合作请联系:ask@cocbang.com 400-115-9001